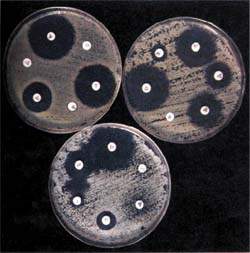

Графики и изображения видов устойчивости бактерий к антибиотикам

Раздел: Фотопутеводитель